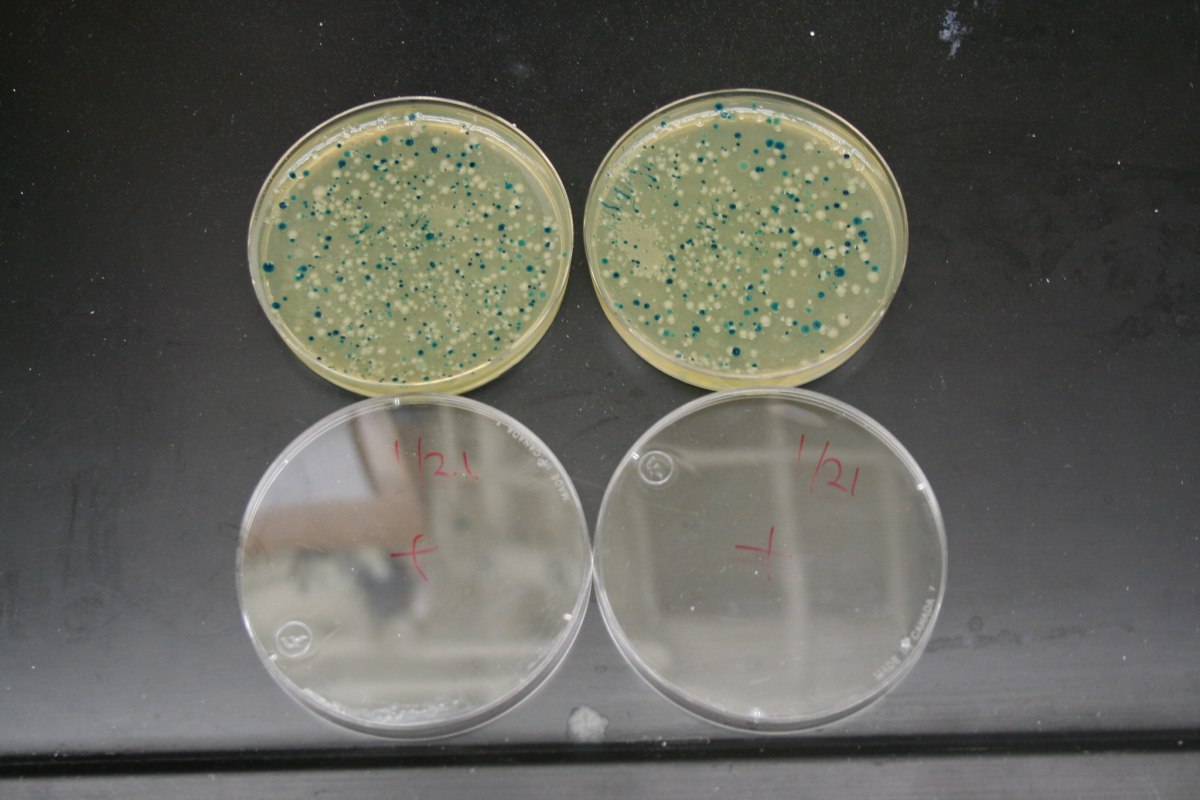

Κίνδυνος στη δημόσια υγεία από την απόσυρση αντιβιοτικού πρώτης γραμμής
Η απόσυρση του μοναδικού αντιβιοτικού τριμεθοπρίμης – σουλφομεθοξαζόλης δημιουργεί προβλήματα αντιμετώπισης σοβαρών λοιμώξεων και εντείνει την ανθεκτικότητα των μικροβίων
Σε κίνδυνο μπαίνουν ασθενείς με σοβαρές λοιμώξεις, εξαιτίας της απόσυρσης από τη χώρα μας του αντιβιοτικού Bactrimel, που περιέχει συνδυασμό τριμεθοπρίμης/σουλφομεθοξαζόλης. Το φάρμακο περιλαμβάνεται στην πρόσφατη λίστα του ΕΟΦ με τα 230 σκευάσματα που αποσύρονται από τη φαρμακευτική αγορά.
Πρόκειται για φάρμακο πρώτης γραμμής, παλαιό και δοκιμασμένο, με δράση σε ευρύ φάσμα λοιμώξεων και η απόσυρσή του από την ελληνική αγορά αναμένεται να ενισχύσει τις ανθεκτικές λοιμώξεις στις οποίες η χώρα διατηρεί δυσάρεστη πρωτιά, εντείνοντας το πρόβλημα δημόσιας υγείας. Ταυτόχρονα αναμένεται να αυξήσει σημαντικά το κόστος για το σύστημα υγείας, καθώς πρόκειται για ένα πολύ φθηνό και αποτελεσματικό φάρμακο, ενώ οι προσπάθειες κάλυψης των ασθενών με άλλα αντιβιοτικά μπορεί να αυξήσει τα φαινόμενα τοξικότητας.
Το συγκεκριμένο αντιβιοτικό, που δίνεται τόσο σε νοσοκομειακούς, όσο και σε εξωνοσοκομειακούς ασθενείς, δεν διαθέτει γενόσημο, με αποτέλεσμα ο ΕΟΦ να επισημαίνει ότι για την προμήθειά του χρειάζεται έκτακτη εισαγωγή μέσω ΙΦΕΤ.
«Η απουσία του αντιβιοτικού οδηγεί στην αδυναμία χορήγησης της βέλτιστης θεραπείας για σοβαρά και δυνητικά θανατηφόρα λοιμώδη νοσήματα»
Η αντικατάσταση του αντιβιοτικού που αποσύρθηκε απαιτεί καλλιέργειες για χρήση αντιβιοτικών νεότερης γενιάς ευρέος φάσματος με κίνδυνο την αυξημένη τοξικότητα
Η ανακοίνωση της απόσυρσης του φαρμάκου πυροδότησε την Ελληνική Εταιρεία Λοιμώξεων (ΕΕΛ), που έκανε λόγο για σημαντικό θεραπευτικό κενό και για κινδύνους για τη δημόσια υγεία, καθώς πρόκειται για μοναδικό και αναντικατάστατο σκεύασμα και έκανε έκκληση για επάνοδο του φαρμάκου σε εμπορική κυκλοφορία.
Το φάρμακο χρησιμοποιείται σε δύσκολα παθογόνα μικρόβια (gram θετικά και αρνητικά) σχεδόν για ολόκληρο τον οργανισμό, καθώς χορηγείται σε λοιμώξεις πνευμόνων, καρδιάς, οστών, μαλακών μορίων, δέρματος, ουροποιητικού, ενώ έχει και τη δυνατότητα αντιμετώπισης λοιμώξεων στο κεντρικό νευρικό σύστημα, καθώς διαπερνά τον εγκεφαλικό φραγμό.
Παράλληλα χορηγείται ως χημειοπροφύλαξη σε ασθενείς με σοβαρά νοσήματα που λαμβάνουν ανοσοκαταστολή, ενώ αποτελεί και βασικό αντιβιοτικό στην παιδιατρική.
Η Εταιρεία Λοιμώξεων επεσήμανε ότι η απουσία της τριμεθοπρίμης/σουλφομεθοξαζόλης οδηγεί στην αδυναμία χορήγησης της βέλτιστης θεραπείας για σοβαρά και δυνητικά θανατηφόρα λοιμώδη νοσήματα σε ευπαθείς ομάδες ασθενών.
Αναντικατάστατο
Σε πολλές περιπτώσεις η χρήση εναλλακτικών αντιβιοτικών συνοδεύεται από χαμηλότερη αποτελεσματικότητα, μεγαλύτερη τοξικότητα και υψηλότερο κόστος, δεδομένου ότι το συγκεκριμένο φάρμακο είναι εξαιρετικά χαμηλού κόστους.
Το ΔΣ της ΕΕΛ επισήμανε τους κινδύνους που ανακύπτουν για τη δημόσια υγεία σημειώνοντας ότι «η απόσυρση του εν λόγω φαρμάκου, τόσο της από του στόματος, όσο και της ενδοφλέβιας μορφής του που προορίζεται για νοσοκομειακή χρήση, δημιουργεί σημαντικό θεραπευτικό κενό για την αντιμετώπιση ποικίλων σοβαρών λοιμώξεων, στις οποίες η χορήγησή του αποτελεί μοναδική και αναντικατάστατη λύση. Αντιλαμβάνεστε λοιπόν το σοβαρό ζήτημα που δημιουργείται για την προάσπιση της υγείας των πολιτών που πάσχουν από τα συγκεκριμένα νοσήματα».
Η ΕΕΛ παρέθεσε ορισμένες κρίσιμες και αναντικατάστατες χρήσεις του, όπως:
- Λοιμώξεις ουροποιητικού από ευαίσθητα μικροβιακά στελέχη. Η απουσία του φαρμάκου θα οδηγήσει σε επιτακτική υποκατάσταση με αντιβιοτικά ευρύτερου φάσματος, με άμεσες επιπτώσεις στην επιβάρυνση της μικροβιακής αντοχής που είναι και μείζον θέμα δημόσιας υγείας.
- Τοξοπλάσμωση της κύησης όπου αποτελεί αντιβιοτικό 2ης γραμμής υποκαθιστώντας το συνδυασμό πυριμεθαμίνης/σουλφαδιαζίνης, όταν δεν γίνεται ανεκτός ή όταν είναι σε έλλειψη, όπως πολύ συχνά συμβαίνει στην Ελλάδα.
- Λοιμώξεις από Nocardia spp οι οποίες απαντώνται σε ευπαθείς ανοσοκατεσταλμένους πληθυσμούς και για τις οποίες αποτελεί το φάρμακο εκλογής με τις εναλλακτικές θεραπευτικές επιλογές να απαιτούν συχνά συνδυασμούς αντιβιοτικών με αυξημένη τοξικότητα και μακρά διάρκεια νοσηλείας.
- Πνευμονία από Pneumocystis jirovecii (PCP) σε ασθενείς με HIV/AIDS, μεταμοσχευμένους και γενικά ανοσοκατεσταλμένους για την οποία αποτελεί θεραπεία πρώτης γραμμής. Επιπρόσθετα χρησιμοποιείται για τους εν λόγω πληθυσμούς και σε μακροχρόνια προφυλακτική χορήγηση για την πρόληψη της PCP, ενώ τα εναλλακτικά σχήματα είναι δυσανάλογα ακριβά και με μεγαλύτερη συχνότητα ανεπιθύμητων ενεργειών.
- Εγκεφαλική Τοξοπλάσμωση για την οποία χρησιμεύει ως κύρια ή εναλλακτική επιλογή θεραπείας και προφύλαξης. Η έλλειψή της της περιορίζει σε σημαντικό βαθμό τις θεραπευτικές επιλογές, αυξάνοντας τον κίνδυνο κακής έκβασης της νόσου.
Οι λοιμώξεις από Nocardia, η εγκεφαλική τοξοπλάσμωση και η πνευμονία από Pneumocysti jirovecii, είναι λοιμώξεις που συνοδεύονται από υψηλή θνητότητα.
- Ηράκλειο: Αγωνία για τον 70χρονο Κώστα Καρτσωνάκη – Εκδόθηκε Silver Alert για την εξαφάνισή του
- Παλλήνη: Χειροπέδες σε 43χρονο που έτρεχε με 191 χλμ/ώρα στην Περιφερειακή Υμηττού
- Κοντά στην αποφυλάκιση ο Ρομπίνιο
- Με ρωγμές το σύστημα ελέγχου για το ελαιόλαδο – Αποκαλυπτικά στοιχεία (γραφήματα)
- Αρκάς: Οι ευχές στους Αντώνηδες και στις Αντωνίες
- Τα νούμερα δεν λένε ψέματα: Πέντα λεπτά άσκηση την ημέρα μπορούν να κάνουν τη διαφορά
- ΗΠΑ: Νεκρή σε τροχαίο με εγκατάλειψη η πρώην παιδική σταρ του Nickelodeon, Κιάνα Άντεργουντ
- Επιστρέφει στην Ελλάδα για τον Πανιώνιο η Χαντάβα (pic)
Ακολουθήστε το in.gr στο Google News και μάθετε πρώτοι όλες τις ειδήσεις







![Άκρως Ζωδιακό: Τα Do’s και Don’ts στα ζώδια σήμερα [Σάββατο 17.01.2026]](https://www.in.gr/wp-content/uploads/2026/01/tamara-badran-H94-jtvjess-unsplash-1-315x220.jpg)















































































Αριθμός Πιστοποίησης Μ.Η.Τ.232442